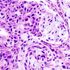

Researchers in Canada have shown for the first time that the incidence of HPV-related oropharyngeal cancers is increasing among the Canadian population.

Your AI-Trained Oncology Knowledge Connection!



Researchers in Canada have shown for the first time that the incidence of HPV-related oropharyngeal cancers is increasing among the Canadian population.

Neck dissection may no longer be the only surgical option for pathologic staging of the neck in patients with oral cavity squamous cell carcinoma, according to a new study.

More than one-third of patients with oropharyngeal cancer were seropositive for HPV16 E6 an average of 6 years prior to their cancer diagnosis compared with less than 1% of healthy controls, a new study has found.
Researchers have developed and tested a nomogram that uses various factors and can predict risk of recurrence in patients with major salivary gland carcinoma.

Prophylactic use of the SSRI escitalopram decreased the occurrence of depression in patients with head and neck cancers by 50% and resulted in significantly improved quality of life for 3 months after drug cessation, according to the results of the PROTECT trial.

A new population-based study of never-smokers shows those with gastric reflux are more likely to be diagnosed with cancers of the throat, including the voice box.

Locoregional recurrences are a major source of morbidity and mortality for patients with squamous cell carcinomas of the head and neck (HNSCC).

Two-year results from the largest randomized trial of IMRT in head and neck cancer confirm that it dramatically reduces the risk of dysphagia and xerostomia. The study was too small to establish a survival advantage, although the results are encouraging.

This paper by Drs. Bhayani, Holsinger, and Lai describes a new approach to an old problem. Advances in the management of head and neck cancer over the past few decades have been made predominantly in the area of non-surgical therapy. Starting with the Veterans Affairs Cooperative Trial for laryngeal cancer in the early 1990’s,[1] advances in the administration of chemotherapy and radiation therapy have enabled patients to forego traditional extensive resections that compromised speech and swallowing function.[2] The advances in combined chemoradiation for advanced head and neck cancer have come with a detriment to some patients in survival and quality of life.[3] Effective treatment, but with decreased morbidity was needed.

A series of promising new advances have emerged in H&N oncology in recent years. Among these are the advancement of highly conformal radiation delivery techniques (e.g. IMRT, protons); the successful introduction of molecular targeted therapies (e.g. cetuximab); the recognition of HPV as a powerful prognostic biomarker; and the development of minimally invasive surgical techniques. The application of transoral robotic surgery (TORS) in H&N cancer is reviewed by Bhayani et al in this issue of ONCOLOGY[1].

The article presented by Bhayani, Holsinger, and Lai thoroughly evaluates the emergence of transoral robotic surgery (TORS) as a technique in the field of otolaryngology. Transoral approaches to the upper aerodigestive tract, whether for diagnostic or therapeutic purposes, represent core tenets of the discipline and formed one of the bases for the inception of the specialty. Innovations and refinements in optics and materials have steadily increased the view, reach, and, consequently the effectiveness of the endoscopic surgeon with each passing decade. In the past thirty years, the introduction of the laser has further enhanced the capabilities of the surgeon, augmenting treatment options beyond open tumor resection and chemoradiation. The introduction of the daVinci robot is an incremental step in the development of techniques that have been evolving over the past one hundred and twenty years.

The evolution of surgical oncologic technology has moved toward reducing patient morbidity without compromising oncologic resection. In head and neck surgery, organ-preserving techniques have paved the way for the development of transoral techniques that remove tumors of the upper aerodigestive tract without external incisions and potentially spare the patient adjuvant treatment. The introduction of transoral robotic surgery (TORS) improves upon current transoral techniques to the oropharynx and supraglottis. This review will report on the evolution of robotic-assisted surgery: We will cover its applications in head and neck surgery by examining early oncologic and functional outcomes, training of surgeons, costs, and future directions.

Head and neck squamous cell carcinoma (HNSCC) represents a heterogeneous group of malignancies caused by the traditional risk factors of tobacco, alcohol, and poor oral hygiene, as well as more recently identified roles of human papillomavirus (HPV) and Epstein-Barr virus (EBV).[1-3] We commend Kim and colleagues on their comprehensive review of the epidemiology of HNSCC. There has been a clear change in the epidemiology of HNSCC which has further accentuated differences in etiology, survival, and demographics among HNSCC patients. We will discuss several important nuances of this changing epidemiology, including the role of tobacco, race, sexual behavior, and gender, as well as HNSCC in nonsmokers and nondrinkers.

As outlined by Leslie Kim and colleagues in this issue of ONCOLOGY,[1] almost 650,000 new cases of head and neck cancer are identified and approximately 350,000 individuals die from this disease worldwide each year. Most cancers of the head and neck are squamous cell carcinomas and originate from one of five major sites: oral cavity, oropharynx, nasopharynx, hypopharynx, and larynx. Traditionally, tobacco smoking and alcohol consumption have been considered to be the main risk factors for head and neck squamous cell carcinoma (HNSCC) and, thus far, most prevention strategies and public health messages have focused on these two factors. However, as described in the review by Kim et al., there is increasing evidence that, independent of tobacco and alcohol exposure, oral human papillomavirus (HPV) infection is a major risk factor for a specific subset of HNSCCs. We agree with the authors that this is an important public health concern, especially given the increasing prevalence of HPV infection in the US and Western Europe and our limited knowledge about the natural history of oral HPV infection. Here we summarize the role of HPV in HNSCC and discuss clinical implications.

Characterizing the epidemiology of head and neck cancers is challenging and has received limited attention in the medical literature. Traditionally, 80%–90% of head and neck squamous cell carcinomas (HNSCCs) have been attributed to tobacco and alcohol use, but with growing public awareness and tobacco control efforts over the past few decades, there has been a downward trend in smoking prevalence in the US. There is also emerging evidence that human papillomavirus (HPV) is responsible for inconsistencies in HNSCC trends, with oncogenic HPV DNA found in approximately half of oropharyngeal cancers and in a high proportion of oropharyngeal cancers in nonsmokers and nondrinkers. The risk to HNSCC epidemiology is that whatever gains continue to be made in tobacco control may become lost in the increasing numbers of oropharyngeal cancers due to HPV. The purpose of this review is to explore the changing epidemiology of HNSCC, focusing on how it has been shaped by health policy and advocacy interventions and how it will continue to have public health implications in the future, particularly in considering preventive strategies against HPV. Given that the majority of HNSCCs are the result of exposure to preventable public health risks, more focus should be given to this area.

Radiation oncologist Jonathan J. Beitler, MD, MBA, offers the radiation oncology perspective on the array of treatment combinations in this complex disease.

Induction chemotherapy has led to improved survival and organ preservation. Combining induction therapy with other treatment modalities is critical for treating this complex disease and attaining optimal outcomes.

A medical oncologist, a radiation oncologist, and a surgeon share pearls and pitfalls in their specialized approaches to managing recurrent disease.

PET paired with a variety of radiotracers offers insights into the metabolic, DNA, and protein pathways.

Removing an oropharyngeal tumor through the open mouth using robotic instruments now has FDA approval, and its safety is well documented. Comparative evidence of its effectiveness is beginning to trickle in.

HOLLYWOOD, FLA.-Two speakers at the 2009 Palm Beach Cancer Symposium agreed that surgery will always play a role in the treatment of squamous-cell head and neck cancers. The question at issue: Is surgery losing ground to chemoradiotherapy as the primary treatment for head and neck cancer?

Quitting smoking during radiation treatment for lung and head and neck cancer significantly enhances treatment efficacy, yet many patients will not give up the habit even though the benefits are very obvious.

Oncologists who treat head and neck cancer face a double-edged sword-life-saving procedures often leave patients disfigured or unable to speak. For Waun Ki Hong, MD, it simply wasn’t enough to offer a cure that was saddled with too many severe consequence

Epidermal growth factor receptor (EGFR) inhibitors have emerged as important drugs in cancer therapy, providing a proven survival advantage for some patients with non–small-cell lung cancer, colorectal cancer, head and neck cancer, and pancreas cancer.

About 500,000 head and neck carcinomas are diagnosed worldwide annually. This accounts for approximately 8% of all newly diagnosed cases of cancer, ranking head and neck carcinoma the sixth most common.[1] In the United States, 47,560 new head and neck carcinomas are expected to be diagnosed in 2008,[2] and this disease accounts for 5% of all newly diagnosed cases of cancer. Approximately 90% to 95% are squamous cell carcinomas of the head and neck (SCCHNs).